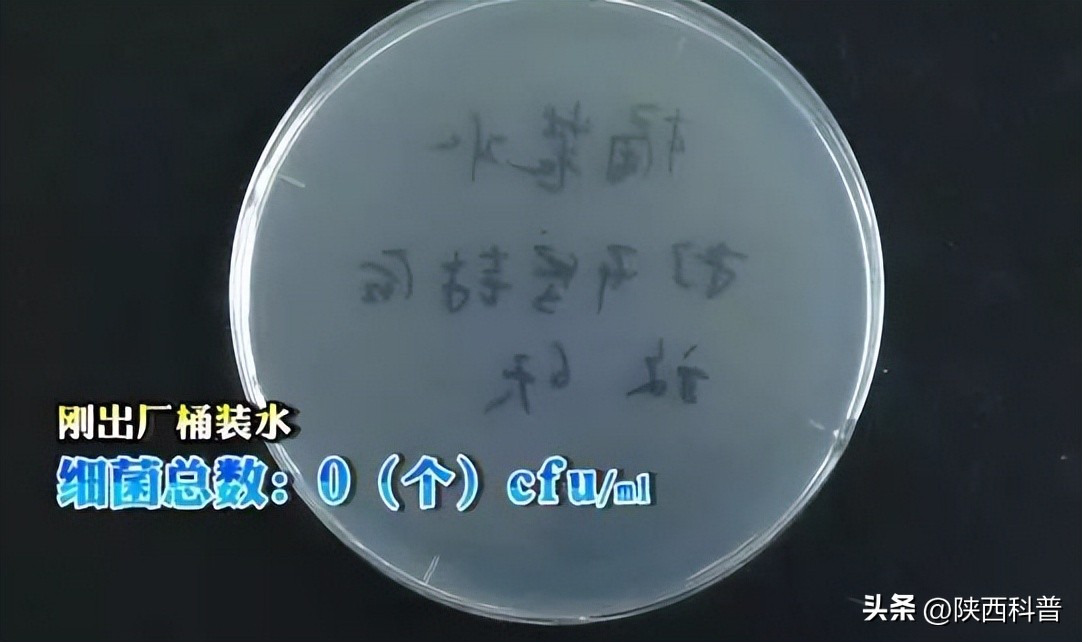
饮水机的水真的有那么脏吗,实测饮水机你想象不到的脏
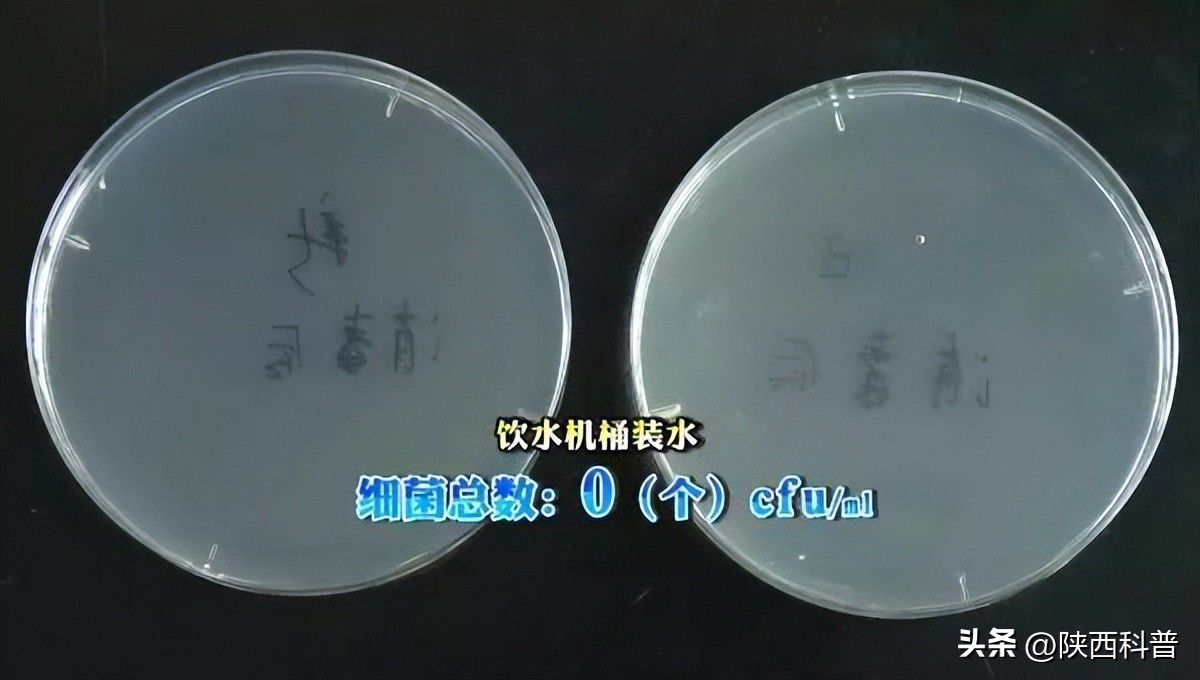
饮水机的水真的有那么脏吗,实测饮水机你想象不到的脏
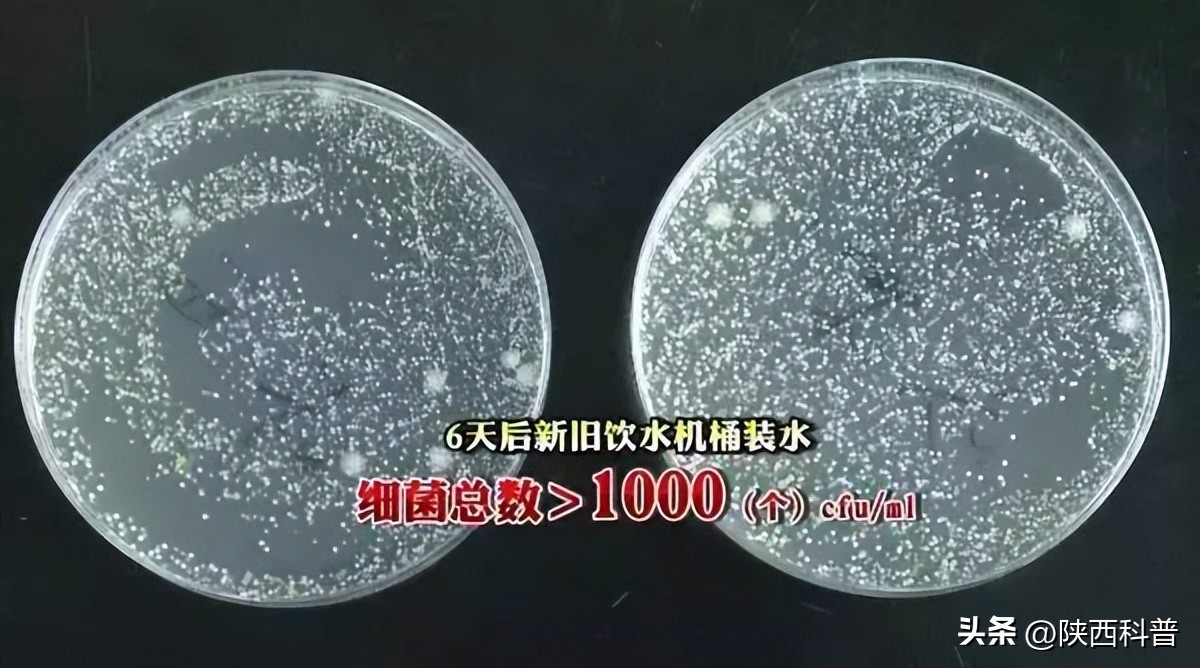
饮水机的水真的有那么脏吗,实测饮水机你想象不到的脏

桶装水+饮水机
是许多家庭和办公场所的必备品
但是很多人对于饮水机的清洗消毒方面
并没有特别在意

网上曾有传言称:“饮水机内的桶装水在开封6天后,细菌总量会严重超标,还不如喝自来水卫生!”这是真的吗?
央视《生活提示》栏目曾做了一个实验:分别检测自来水和桶装水内的菌落总数,结果发现, 饮水机上的桶装水开封三天,细菌含量远高于自来水 。
今天我们来研究一下:
饮水机里的水干净吗?
饮水机里的水是如何被污染的?
如何清洗饮水机?
饮水机里的水
央视新闻曾报道过一项关于水质检测的实验:
研究团队先取样部分普通的自来水,经过24小时后,发现 自来水样本中的细菌含量是1个/ml 。而国标对生活饮用水的细菌规定是:每100ml饮用水中细菌总数不得超过100个,因此就细菌数而言,自来水还是很干净的。
随后研究人员挑选了一款 出厂5天的桶装水 ,对其出水口进行消毒并采集样本。经检测发现,此桶装水的 细菌为0个/ml 。

自来水
桶装水
图源央视新闻
这样干净的桶装水,装到饮水机上怎么就细菌超标了呢?
研究人员找了两台饮水机,一台为全新的,一台是用了三年,半年前才清洗过的旧饮水机。
为保证实验结果准确,先用烧开的沸水冲洗和浸泡饮水机内管三遍,随后用75%的酒精对饮水机内腔以及出水口消毒,最后放上桶装水,分别从冷水口和热水口放出500ml水冲洗饮水机内部管路。
清洗完毕后取样检测,发现两款饮水机的细菌总数都是0个/ml,说明两台饮水机里的水目前都没有被污染。 但是把桶装水放在饮水机上静置6天后,再取样检测,结果发现这两桶水中的细菌总数都大于1000个/ml 。
清洗后
图源央视新闻
《生活饮用水标准》GB5749-85规定: 每100ml饮用水中的细菌总数不得超过100个 。显然,在饮水机上放置6天后的桶装水,已经完全达不到国家生活饮用水标准!
水是如何被污染的
1、空气里的细菌
浙江省人民医院检测中心主管技师朱永泽表示:“空气中的细菌只有吸附到某个平台后才会繁殖,而桶装水与饮水机的交界面,由于空气湿润,刚好给细菌的繁殖提供了理想环境。”
桶装水装上饮水机后, 每放出一升水就会有相应体积的空气进入 ,而空气中夹带各种细菌微生物也随之附着在饮水机内部。

图源网络
2、内胆里的陈水
人们喝完水后只重新换上一桶,忽视了内胆约1000毫升的水,时间长了,内胆也成了细菌生长的“温床”。
如果清洗不到位,细菌增长繁殖就会出现“二次污染”。长期喝下这样的水,可能引起人的 肠胃不适、甚至腹痛、腹泻,严重的可能导致尿路感染 等。因此,定期对饮水机进行清洗和消毒至关重要。
如何清洗饮水机
一般情况下,水有异味、饮水机水流变小、烧开水时间延长,都是需要清洗的信号。家用饮水机最好3~4个月清洗一次,可以请专业清洗饮水机的人员上门清洗,也可以自己在家清洗。

图源网络
1、断电、排水
切断饮水机电源,取下水桶,放空饮水机腔内的剩余水,特别注意要打开饮水机背后的排污管,将剩余水彻底排净。
2、用清洗液清洁饮水机
用中性清洁剂清洗机体表面、聪明座和托盘等部件,用镊子夹住酒精棉花,仔细擦洗饮水机机芯和盖子的内外侧。

3、消毒
可选用对人体无害且不影响水质的消毒剂,倒入内胆,作用10-20分钟后,打开全部出水口包括排污管,彻底排净消毒液。
4、反复冲洗
打开饮水机的所有开关,包括排污管和饮水开关,并用清水连续冲洗饮水机整个腔体,打开所有开关排净冲洗液体,反复冲洗多次,直至没有异味后即可恢复使用。
此外,过滤型饮水机通常不能拆开清洗,建议按说明书要求清洗,每1~2年更换一次滤芯,清洗时还应注意清洁机器表面。

图源网络
还需要注意的是,饮水机在使用的过程中,进水口会与空气接触,如果饮水机周围的空气质量比较差,势必会严重影响到水的质量。
建议家里饮水机最好不要摆放在靠近阳台、窗口等阳光直晒的位置,厨房油烟比较大也不适合摆放,也不要摆放在卧室里。如果是公共区域的饮水机,要避免摆放在人口密集的地方,也不要摆放在打印机、复印机、垃圾篓等的旁边。
饮水机最好放在避光处或为水桶加罩避光桶套,并保持周围环境整洁 。
来源:陕西科普